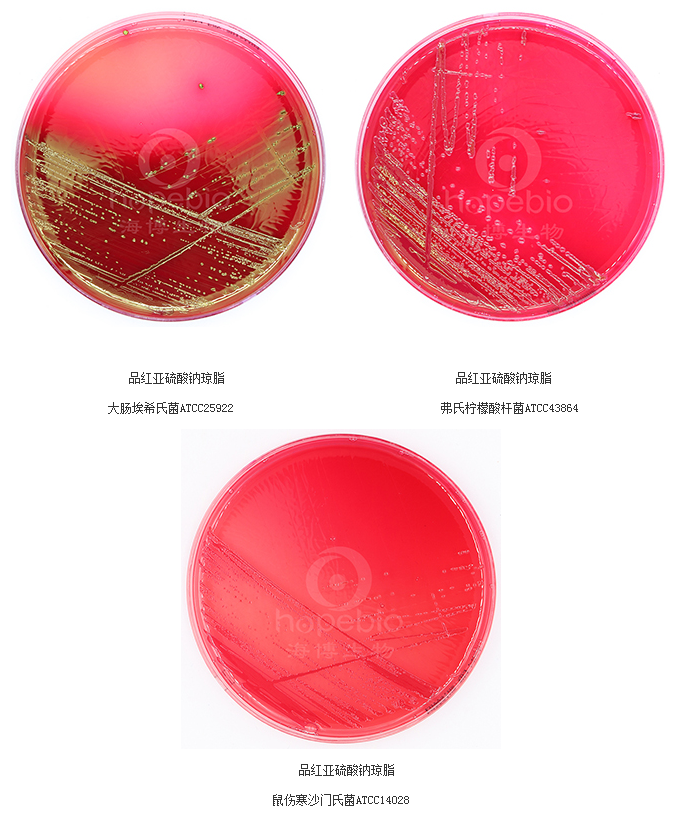
46860365.png

电话:13001385296
QQ:2105131983
办公:天津市武清区京滨工业园
基本信息
成分组成
产品特性
检验原理:蛋白胨、酵母粉、牛肉粉提供碳氮源、维生素和矿物质等营养成分。乳糖为可发酵糖类,细菌发酵乳糖产生乙醛,在碱性品红存在的情况下,乙醛与亚硫酸钠结合形成红色菌落,快速发酵乳糖的细菌产生金属光泽,不发酵乳糖的细菌则形成无色透明菌落,从而实现对总大肠菌群的选择性分离和确证。
注意事项
不同细菌在品红亚硫酸钠琼脂平板上的生长特征:
品红亚硫酸钠琼脂平板微生物灵敏度试验:
接种以下质控菌株,放置36±1℃需氧培养24±2小时。


